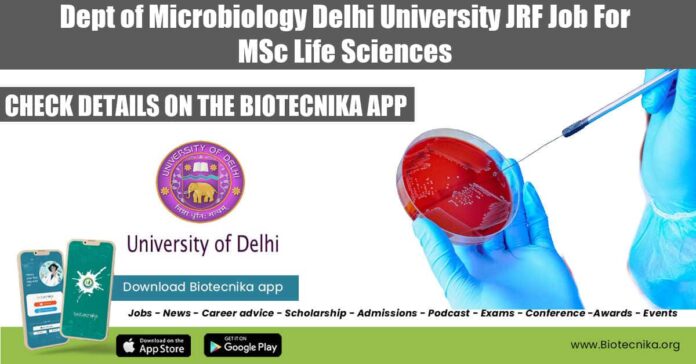

Delhi University Vacancy 2022 For MSc Life Sciences, Applications Invited
Delhi University Vacancy 2022 For MSc Life Sciences, Applications Invited. The University of Delhi is hiring for research position. Junior Research Fellow job for MSc Life Sciences are available for candidates at the University of Delhi. Check out all of the details below –
This job expires in
Department of Microbiology
University of Delhi, South Campus
Benito Juarez Road, Delhi-110021
No: UDSC/Micro/RK/07/11
Applications are invited for appointment on an ad-hoc basis for the temporary p_osi t ion in extramural funded Projects. The duration of appointments will be only till the duration of the Projects. The details regarding essential and desirable qualifications and salary are given in table below.
Name of the Post – Junior Research Fellow
No. of Posts – 01
Name of the Project – DST- SERB funded “Center of Antibody Engineering: Center for Immuno-Diagnostics/ Therapeutics Veneering technologies (CIVET)”
How to Apply –
- The age limit for JRF is 35 years and for Technician/ Lab-attendant is 50 years as of the last date of application.
- The posts are purely temporary and will be filled on a contractual basis only and will be co-terminus with the project.
- The application can be sent only by email within 21 days of publication of this advertisement to [email protected].
- The subject line of the email should mention the applicant’s name and the name of the position applied for. The shortlisted applicant will be interviewed through Google Meet for which all communications will be sent by email only.
The last date of Application is 21 days from the date of publication (02-Aug-2022)
Eligibility – Post-graduate degree in any branch of Life sciences,
Desirable Qualification – Preferably with at least 2 years of experience working in a Microbiology research lab using molecular biology techniques.
Emoluments – JRF (Rs.31,000 + 24%HRA)
Click here for the notification
Editor’s Note: Delhi University Vacancy 2022 For MSc Life Sciences, Applications Invited. Please make sure that you are subscribed to the Biotecnika Times Newsletter and our YouTube channel to be notified of all of the latest in the industry. Follow us on all of our social media like Twitter, Telegram, Facebook and Instagram.